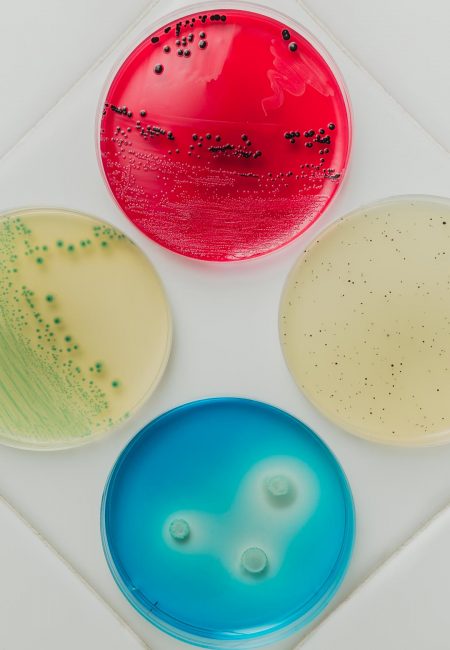
ENRICOMONNISTUDIO_ENR_6069-Modifica_INSES_LOW-Q_18

Sicurezza Alimentare
Le analisi sugli alimenti sono uno dei metodi riconosciuti dalla normativa per validare i sistemi HACCP.
La normativa di riferimento è il cosiddetto pacchetto igiene (Regolamenti CE n. 852, 853, 854, 882/2004, e Direttiva 2002/99), recepito in Italia dal DLgs 193/2007.
Sono anche uno degli strumenti fondamentali per verificare e controllare materie prime o fornitori.
Le analisi effettuate su semilavorati alimentari, o su superfici a contatto con gli alimenti (MOCA), o sulle mani degli operatori che manipolano alimenti, sono uno strumento per validare processi produttivi o programmi di prerequisiti PRP quali ad esempio i processi di sanificazione.
Attraverso un controllo analitico sugli alimenti è possibile inoltre definire i valori nutrizionali secondo le diverse normative applicabili.

Analisi Chimiche
Le analisi chimiche sono fondamentali per rilevare i contaminanti chimici che possono mettere a rischio la salute umana, la salubrità di un alimento, o un ecosistema ambientale.
Tali contaminanti sono molti e di diversa natura, come molteplici possono essere le fonti della contaminazione.

Qualità e Valori Nutrizionali
Le analisi nutrizionali di laboratorio forniscono i valori che dovranno essere riportati sull’etichetta degli alimenti, in quanto tutte le aziende di produzione alimenti hanno l’obbligo di inserire in etichetta la dichiarazione nutrizionale.

Analisi Microbiologiche
Eseguiamo analisi microbiologiche su alimenti, acque potabili e tamponi.
E supportiamo le aziende nella definizione dei Piani di Campionamento e relativa frequenza in base all’analisi dei pericoli, dati storici aziendali, produttività, mercato di riferimento.
Criteri di Analisi Microbiologiche
Seguendo gli orientamenti di quanto previsto da Reg CE 2073/05 e in base all’analisi dei pericoli delle principali matrici, siamo in grado di supportare le aziende nella scelta dei parametri microbiologici da verificare sia per i criteri di sicurezza sia di igiene del processo.
Criteri di igiene del processo – Definisce il funzionamento accettabile del processo di produzione.
Questo criterio, che non si applica ai prodotti immessi sul mercato, fissa un valore indicativo di contaminazione al di sopra del quale sono necessarie misure correttive volte a mantenere l’igiene del processo di produzione in ottemperanza alla legislazione in materia di prodotti alimentari.
Variano a seconda della categoria di alimenti, in generale possiamo identificare:
- conteggio delle colonie aerobiche,
- Escherichia coli,
- Stafilococchi coag. Positivi,
- enterobatteriaceae,
- bacillus cereus.
Criteri di sicurezza alimentare – Si tratta di un criterio che definisce l’accettabilità di un prodotto o di una partita di prodotti alimentari, ed è applicabile ai prodotti immessi sul mercato. Sono dei criteri che permettono di stabilire se un prodotto alimentare è sicuro oppure no.
Variano a seconda della categoria di alimenti, in generale possiamo identificare:
- Listeria monocytogenes;
- Salmonella,
- Escherichia coli,
- Istamina,
- Enterotossine stafilococciche.
I parametri microbiologici possono distinguersi principalmente in ceppi patogeni e ceppi alteranti.

Biologia Molecolare
Il nostro obbiettivo principale è la soddisfazione del cliente cercando di essere sempre all’avanguardia con macchinari di ultima generazione; per quanto riguarda il settore agroalimentare, uno degli ultimi investimenti riguarda la ricerca dei germi patogeni con la tecnica della PCR Real-time, che lavora direttamente sul DNA del campione. Riusciamo così a comunicare in 24 ore l’esito dell’analisi direttamente al cliente, accorciando i tempi di attesa previsti dalla metodica tradizionale.

